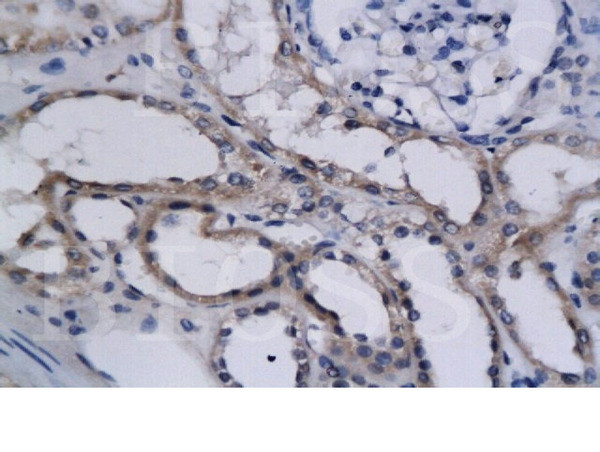
HIF2 alpha Antibody in Immunohistochemistry (Paraffin) (IHC (P))

Search
Bioss
HIF2 alpha Polyclonal Antibody
{{$productOrderCtrl.translations['antibody.pdp.commerceCard.promotion.promotions']}}
{{$productOrderCtrl.translations['antibody.pdp.commerceCard.promotion.viewpromo']}}
{{$productOrderCtrl.translations['antibody.pdp.commerceCard.promotion.promocode']}}: {{promo.promoCode}} {{promo.promoTitle}} {{promo.promoDescription}}. {{$productOrderCtrl.translations['antibody.pdp.commerceCard.promotion.learnmore']}}
产品信息
BS-1447R
种属反应
宿主/亚型
分类
类型
抗原
偶联物
形式
浓度
规格
纯化类型
保存液
内含物
保存条件
运输条件
靶标信息
HIF-2 alpha (Epas1) is a transcription factor involved in the induction of genes regulated by oxygen. HIF-2 alpha contains a basic-helix-loop-helix domain protein dimerization domain as well as a domain found in proteins in signal transduction pathways which respond to oxygen levels. It also regulates the vascular endothelial growth factor (VEGF) expression and seems to be implicated in the development of blood vessels and the tubular system of the lungs. Mutations in this gene are associated with erythrocytosis familial type 4.
仅用于科研。不用于诊断过程。未经明确授权不得转售。
篇参考文献 (0)
生物信息学
蛋白别名: Basic-helix-loop-helix-PAS protein MOP2; bHLHe73; Class E basic helix-loop-helix protein 73; Endothelial PAS domain-containing protein 1; EPAS; EPAS-1; Hif like protein; HIF-1-alpha-like factor; HIF-1alpha-like factor; HIF-2 alpha; HIF-2-alpha; HIF-2alpha; HIF-related factor; HIF1 alpha-like factor; HIF1alpha-like factor; HIF2 alpha; HIF2-alpha; HLF; HLF (HIF1alpha-like factor); HRF; hypoxia inducible factor 2, alpha subunit; hypoxia inducible factor 2a; hypoxia inducible transcription factor 2alpha; hypoxia-inducible factor 2 alpha; Hypoxia-inducible factor 2-alpha; Member of PAS protein 2; mHLF; PAS domain-containing protein 2; unnamed protein product
基因别名: BHLHE73; ECYT4; EPAS; EPAS1; HIF-2alpha; HIF2A; HLF; HRF; MOP2; PASD2
UniProt ID: (Human) Q99814, (Mouse) P97481, (Rat) Q9JHS1
Entrez Gene ID: (Sheep) 443286, (Human) 2034, (Mouse) 13819, (Rat) 29452